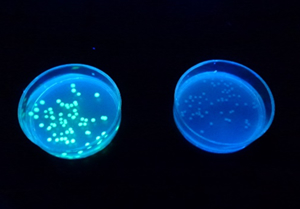

授業実践記録(生物)
大腸菌の形質転換実験
-オワンクラゲの発光タンパク質遺伝子の大腸菌への導入-

1.はじめに
近年,遺伝子の構造と機能に関する研究は飛躍的に進展し,ゲノム創薬やオーダーメード医療などが現実の時代となってきた。生命科学の情報はテレビや新聞,雑誌で紹介されることも多く,正しい知識や概念をもつことが大変重要になってきている。遺伝子発現の仕組みについては実験が難しかったが,最近では高等学校でも実験可能なキットが発売されている。本稿ではその実践例を紹介したい。
この実験を行うにあたっては法令に基づく拡散防止措置を取らなければならないが,その理由や遺伝子を扱う際の注意点(安全指導)をしっかりと事前に理解させてから行うことが重要である。事前指導をしっかりと行った上で実験すれば,多くの生徒が大腸菌のコロニーに紫外線を当てたときに見られる緑色蛍光色に感動するだろう。
2.実験の概要
この実験の概要は以下のとおりである。
オワンクラゲの持つ緑色蛍光タンパク質(Green Fluorescent Protein ;GFP)遺伝子と,抗生物質に対する耐性遺伝子を,ベクターとしてプラスミドを使って大腸菌に導入する。プラスミドはBio-Rad社から売り出されているキットを使用した(理科教材会社から購入できる)。これらの遺伝子が発現すると,大腸菌はそれまで持っていなかったオワンクラゲの緑色蛍光タンパク質を作り出し,紫外線を当てると光るようになる。また,抗生物質(実験ではアンピシリンを使う)を入れた培地でも,耐性遺伝子が発現し抗生物質が効かなくなり,コロニーができる。つまり大腸菌に形質転換が起きる。
目に見えない遺伝子が発現し,目に見える形でコロニーができたり,発光したりするので容易に結果を確認でき,さまざまな考察ができる実験でもある。
(1) 事前準備
実験で使う培地は3種類である。LB培地が基本であるが,それにアンピシリンという抗生物質を加えた培地,LB培地にアンピシリンとアラビノース(単糖)を加えた培地である。培地は実験数日前に教師が作ったが,高校3年生でこの実験を行う場合などは,無菌操作の技術を体験させるために作らせてもよい。培地はある程度乾燥してから冷蔵庫で保管する。大腸菌はLB培地にまいて培養するが,これは実験16時間~20時間前に行う(授業が翌日の何時間目にあるかで,大腸菌をまく時間が異なるので注意が必要)。
(2) 実験当日
![]() (図1) プラスミドをマイクロチューブに入れる |
![]() (図2) ヒートショックを与える |
実験当日はプラスミドの入った小瓶(キットに含まれている)に形質転換溶液を入れ,冷蔵保管しておく。氷温に冷やしたマイクロチューブを2本用意し(+と書いたほうがプラスミドを導入するチューブ,-と書いたほうはプラスミドを入れないチューブ),両方にスタータープレートから大腸菌を入れる。次に+と書いたチューブのみにプラスミドを入れ(図1),ヒートショックという方法(図2)でプラスミドを大腸菌に導入する。この方法は,マイクロチューブを氷温に冷やした後,42℃のウオーターバスに50秒間入れ,すぐに氷温に戻すものである。その後室温で10分間休ませてから液体のLB培地を加え,シャーレ(プレート)にまいて培養する。10分間休ませている間にプラスミドの入った大腸菌はアンピシリン分解酵素(βラクタマーゼ)を合成し,アンピシリン入りの培地でも生育可能になる。
+チューブからはLBとアンピシリンの入った培地(①),さらにそれにアラビノースを加えた培地(②)にまき,-チューブからはLB培地(③),LBとアンピシリンの入った培地(④)にそれぞれまく。まいた後,ループという器具を使いうすく広げ,インキュベータで37℃,24時間培養する。
(3) 結果の確認
翌日以降,培地を肉眼で観察し,さらに紫外線を照射して,発光するかしないかを確認する(図3)。
![]() (図3) 紫外線を当てて発光を確認 |
![]() (図4)アラビノースの入った培地のみ発光する |
①(プラスミドを導入して,LBとアンピシリンの入った培地で培養)は,アンピシリンが含まれているので本来大腸菌は生育できないが,導入したプラスミドの抗生物質耐性遺伝子が発現し,アンピシリンを分解するため生育できる(図4右)。②(プラスミドを導入して,LBとアンピシリンとアラビノースの入った培地で培養)は同様に生育でき,紫外線照射によって発光する(図4左)。
①と②の違いは,どちらも導入したプラスミドにはGFP遺伝子が存在するが,アラビノースの存在下でのみプロモーターにRNAポリメラーゼが結合しGFPが転写されるので②だけが光る。つまりアラビノースが転写開始のスイッチのような役割をしている。遺伝子は存在するだけでは働かないことが体験できる。時間があれば①の培地(大腸菌のコロニーはできるが光らない)にアラビノースを滴下してみると,半日後には滴下した部分のみ発光することが確認できる。
③(プラスミドを入れないで,LB培地で培養)は一面に大腸菌が生育し,④(プラスミドを入れないで,LBとアンピシリンの入った培地で培養)はアンピシリンが効いて全く生育できないことがわかる。
3.本校での実践
本校では高等学校1年生の「生物基礎」において,全員この実験を行っている。実験は2時間続きで行うが,実験自体は1時間15分程度で終わる。また,培地を作るための事前準備(高校1年生は教師が培地を作る)と,実験24時間以降に結果を見るための実験が必要である。
この実験はキットを購入すれば必要な器具,薬品はほとんど含まれている。実験はP1レベルの拡散防止措置を取らなければならないが,高価な備品はなくてもできる。遺伝子組換え生物とそれが付いた器具類はオートクレーブで121℃,20分間加圧滅菌し,不活性化させてから廃棄することと定められているが,圧力鍋でも代用できる。生徒には安全指導上必ず白衣を着用させ,実験前後には手を十分洗ったのち,70%エタノールでその都度消毒しながら行わせるようにする。
微生物を扱う実験なので緊張感をもって行ってもらうため,十分な事前指導が必要ではあるが,どの生徒もこの実験が1年間で最も厳しく,しかし最もやりがいのある実験だったと述べている。この実験をきっかけとして,遺伝子組換え食品や遺伝子治療などバイオテクノロジーの最先端技術と倫理面からのアプローチをより詳しく追究してほしいと思う。
参考文献
- (1)高等学校等において教育目的で行われる遺伝子組換え実験の「遺伝子組換え生物等の使用等の規則による生物の多様性の確保に関する法律」における取扱いについて 文部科学省通知 平成16年2月18日(15文科振第946号)
- (2)髙橋伸一郎・石田大喜 文部科学省における組換えDNA実験指針の法制化と教育目的実験 ―実際に教育目的実験を始める前に― 遺伝別冊18号(2005):151-153
- (3)斎藤淳一 教育目的組換えDNA実験について 高校理科研究No.5(2003) 大日本図書